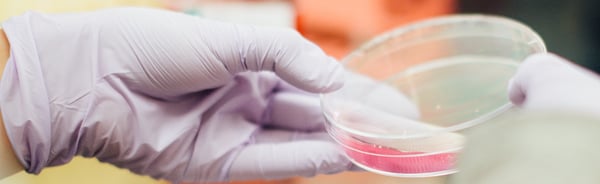

Comportement sédentaire au bureau : voici quelques astuces pour que vos travailleurs soient assis moins souvent
26 novembre 2018 | Temps de lecture : 4 min.
Le corps humain n’est pas fait pour rester longtemps assis. Or, nous passons la plus grande partie de la journée...
Lire la suite